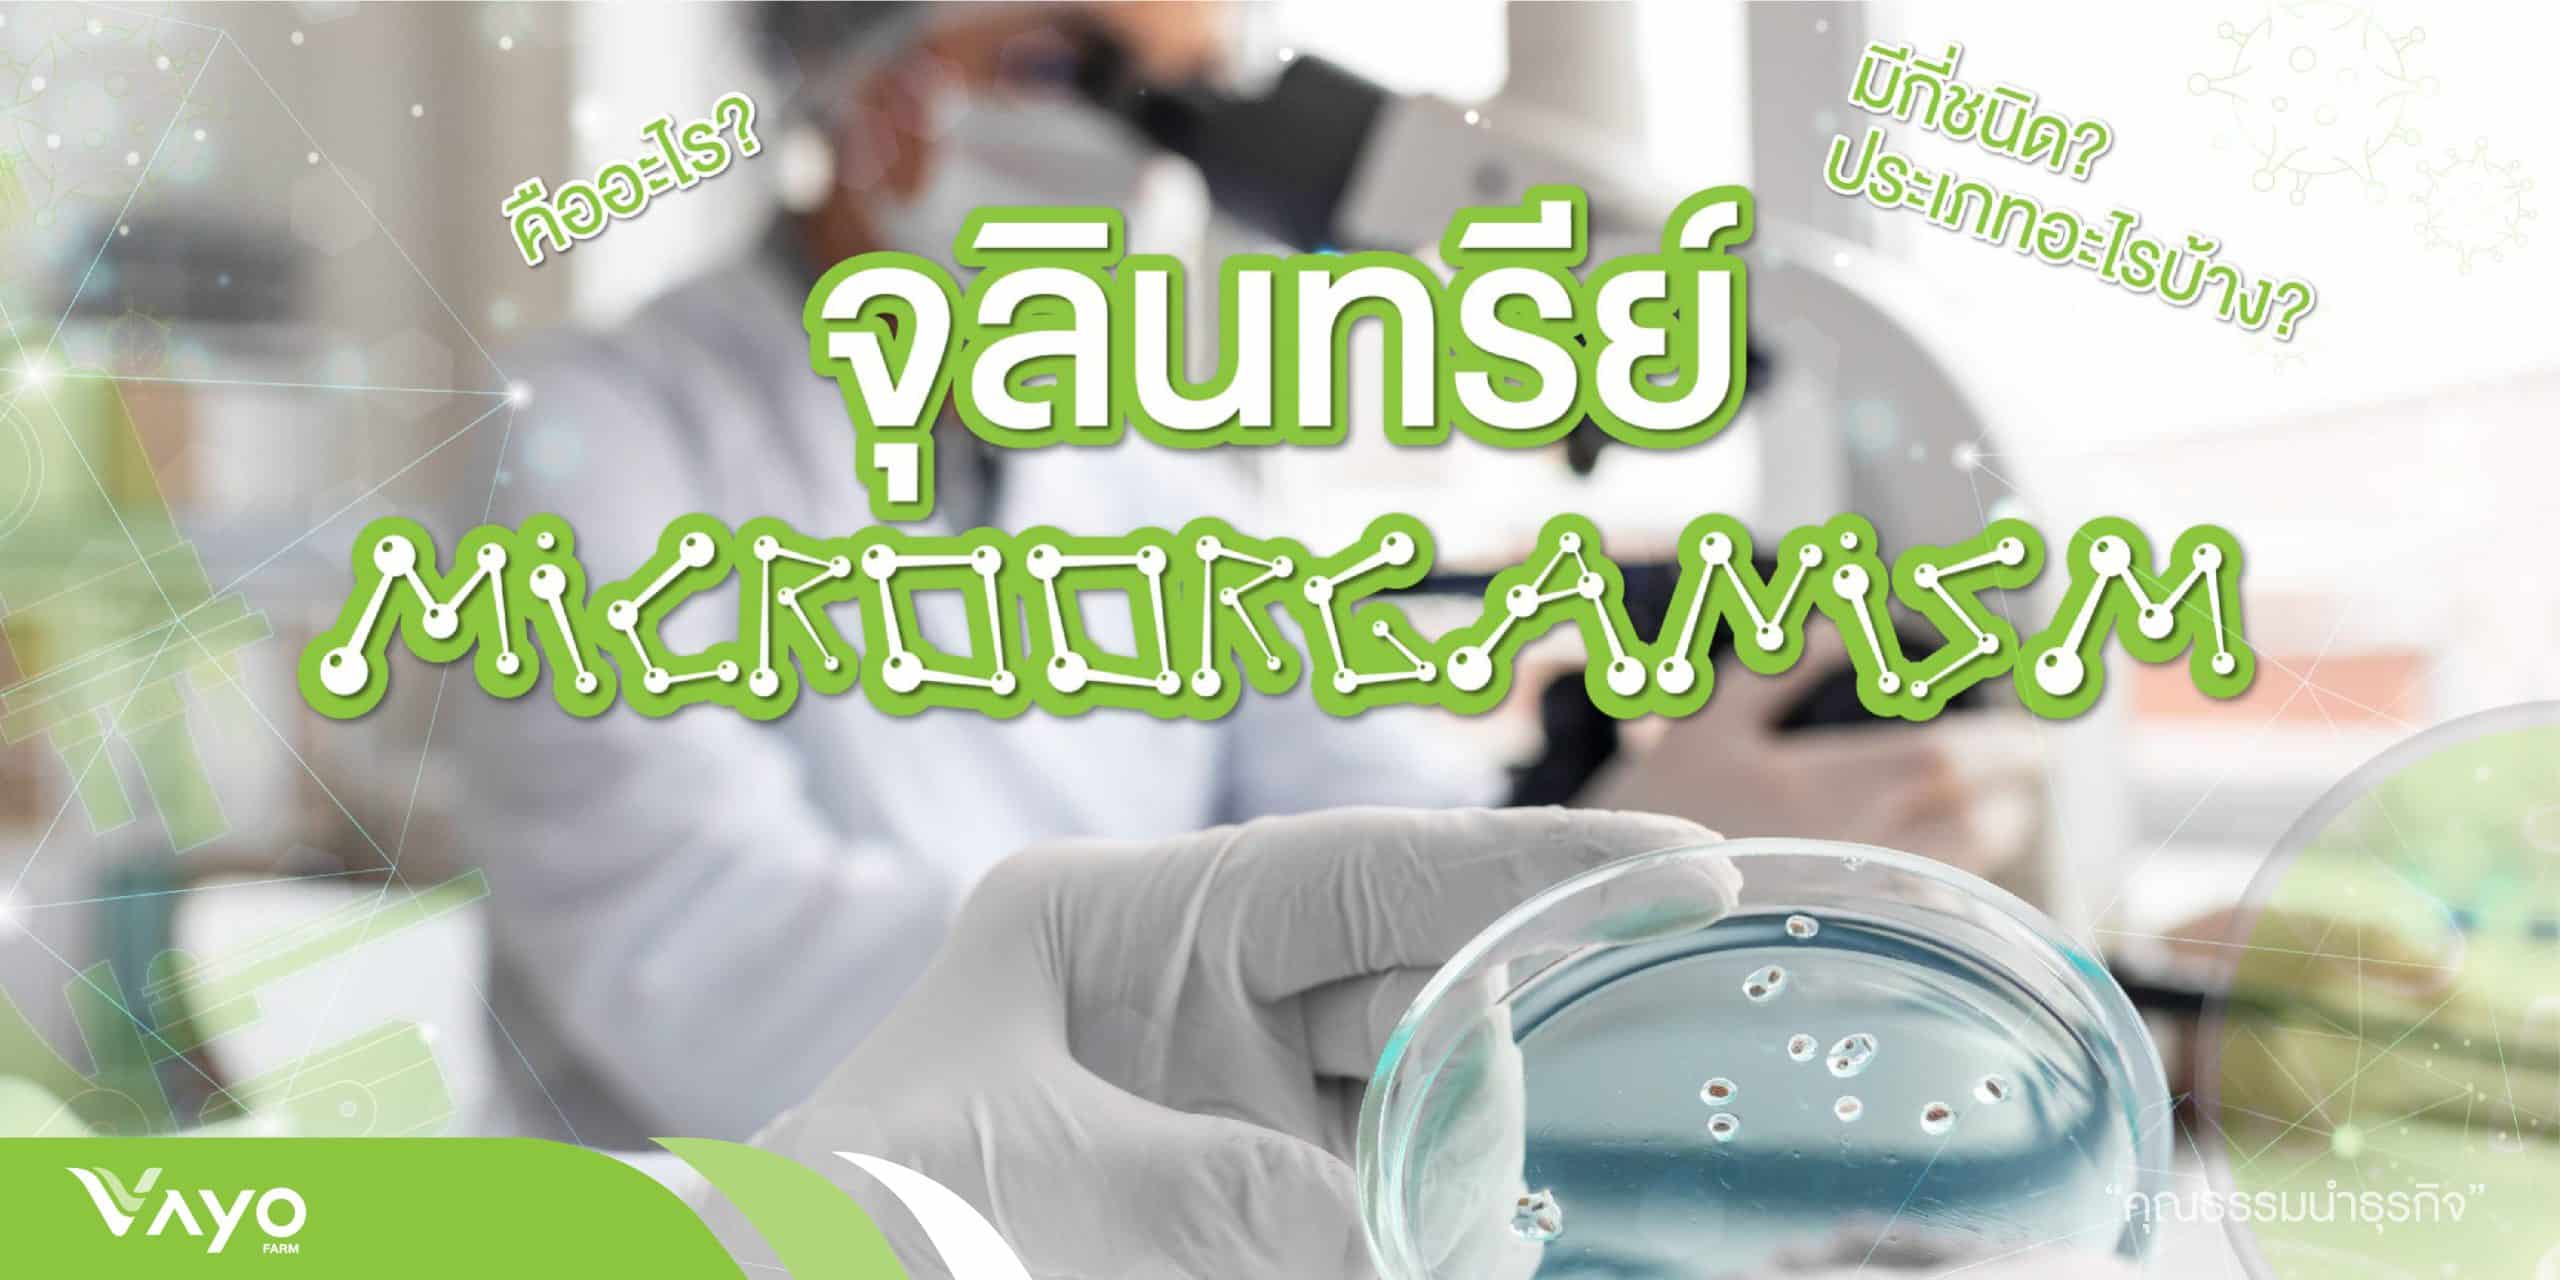

จุลินทรีย์ (Microorganism) คือสิ่งมีชีวิตมองด้วยตาเปล่าไม่เห็น เป็นสิ่งมีชีวิตขนาดเล็กที่ประกอบด้วยเซลล์เดียว (Unicellular) หรือหลายเซล์ (Multicellular) แต่ทว่าเซลล์เหล่านั้นต่างก็เป็นเซลล์ชนิดเดียวกันและมีรูปร่างเหมือนกัน ไม่มีการเปลี่ยนแปลงของเซลล์เพื่อทำหน้าที่เฉพาะเหมือนในสิ่งมีชีวิตชั้นสูง จุลินทรีย์สามารถแบ่งออกเป็น 2 กลุ่มใหญ่ๆ ตามประเภทของเซลล์ คือ
1.โปรคารีโอต คือ ไม่มีเยื่อหุ้มนิวเคลียส เช่น แบคทีเรียและสาหร่ายสีเขียวแกมน้ำเงิน
2.ยูคารีโอต คือ มีเยื่อหุ้มนิวเคลียส เช่น เชื้อรา โปรโตซัว และสาหร่ายต่างๆ ยกเว้นสาหร่ายสีเขียวแกมน้ำเงิน
ประเภทของจุลินทรีย์
1. แบคทีเรีย (Bacteria)
2. เชื้อรา (Fungi)
3. โปรโตซัว (Protozoa)
4. สาหร่าย (Algae)
5. ไวรัส (Virus)

จุลินทรีย์ 7 กลุ่ม ที่มีประโยชน์ต่อเกษตรอินทรีย์
- จุลินทรีย์แบคทีเรีย (Bacteria)
- จุลินทรีย์ กลุ่มที่เป็นเชื้อรา (Funji)
- จุลินทรีย์เชื้อรา กลุ่มยีสต์ (Yeasts)
- จุลินทรียเชื้อรา กลุ่มที่เป็นราเส้นใย
- จุลินทรีย์แอคติโนมัยซิท
- จุลินทรีย์ที่เป็น สาหร่ายสีเขียวแกมน้ำเงิน
- จุลินทรีย์โปรโตซัว (Protozoa)
1. จุลินทรีย์กลุ่มแบคทีเรีย (Bacteria)
จุลินทรีย์กลุ่มนี้มีหลากหลายสายพันธุ์ ที่รวมตัวกันอยู่ในกองปุ๋ยหมัก และในหัวเชื้อจุลินทรีย์ที่ทำขายเป็นการค้า มักมีลักษณะรูปร่างของจุลินทรีย์เป็นแบบง่ายๆ 3 รูปร่าง คือ กลม เป็นท่อน และเป็นเกลียว ไม่มีรงควัตถุภายในเซลล์ คือ เซลล์มักจะเป็นลักษณะใสๆ มีทั้งเคลื่อนที่ได้และไม่ได้ เติบโตได้ในอุณหภูมิหลายระดับ โดยขึ้นอยู่กับสายพันธุ์ มีทั้งแบบที่ต้องการออกซิเจน และไม่ต้องการออกซิเจน อาศัยอยู่ทั่วไปในธรรมชาติ โดยเฉพาะในดินป่าที่ชื้น มีบทบาทอย่างมากในการย่อยสลายอินทรียวัตถุและปลดปล่อยธาตุอาหารที่สำคัญให้กับพืช ตัวอย่างของแบคทีเรียที่เรารู้จักคุ้นหูกันดี เช่น บาซิลลัสทูริงจิเอนซิส หรือเรียกสั้นๆ ว่าเชื้อบีที เชื้อแลคโตบาซิลลัส จุลินทรีย์สังเคราะห์แสง (โฟโต้ทรอปฟิคแบคทีเรีย) จุลินทรีย์ผลิตกรดแลคติกและกรดอะซิติก เชื้อไรโซเบียม ฯลฯ
2. จุลินทรีย์กลุ่มที่เป็นเชื้อรา (Funji)
จุลินทรีย์กลุ่มเชื้อรามักจะพบในกองปุ๋ยหมักเสมอ มักจะพบเติบโตในช่วงแรกๆ ของการหมักกองปุ๋ย และจะพบบริเวณด้านนอกผิวของกองปุ๋ยหมักเป็นจำนวนมาก เมื่อกองปุ๋ยหมักมีอุณหภูมิสูงขึ้นถึง 65 องศาเซลเซียส จะไม่พบเชื้อรา แต่จะพบเชื้อแบคทีเรียแทน เชื่อราจะมีประโยชน์ในการย่อยสลายเศษวัสดุอินทรีย์ในกองปุ๋ยหมักให้มีขนาดเล็กลงในระยะแรกๆ ของการหมักปุ๋ย จุลินทรีย์ที่เป็นเชื้อราแบ่งออกเป็น 2 ชนิด คือยีสต์ ( Yeasts ) และราเส้นใย
3. จุลินทรีย์เชื้อรากลุ่มยีสต์ (Yeasts)
ยีสต์ เป็นเชื้อราซึ่งมีลักษณะการดำรงชีวิตอยู่ในสภาพเซลล์เดียว แทนที่จะเจริญเติบโตเป็นเส้นใยเหมือนเชื้อราอื่นๆ ทั่วไป ถึงแม้ยีสต์บางชนิดจะสร้างเส้นใยบ้างแต่ก็ไม่เด่นชัด การเพิ่มจำนวนจะอาศัยการแบ่งตัวหรือแตกหน่อไม่อาศัยเพศ มีรูปร่างกลมเมื่ออายุน้อย และรูปร่างรีเมื่ออายุมาก มีขนาดที่ใหญ่กว่าเชื้อแบคทีเรีย ยีสต์ทำให้เกิดกระบวนการหมักโดยจะเปลี่ยนน้ำตาลให้เป็นเอทิลแอลกอฮอล์ และคาร์บอนไดออกไซด์ ปกติยีสต์จะอยู่ที่ผิวหน้าของวัสดุที่หมัก โดยจะเป็นฟองที่ลอยเป็นฝ้าอยู่ที่ผิวของน้ำหมัก นอกจากนี้ยีสต์ยังผลิตวิตามิน และฮอร์โมนในระหว่างกระบวนการหมักด้วย และยีสต์จะสามารถเจริญเติบโตได้ดีในค่าความเป็นกรดสูงระหว่าง 4.0 – 6.5 ซึ่งที่ค่าความเป็นกรด-ด่างขนาดนี้นั้น จุลินทรีย์ที่ก่อให้เกิดการเน่าเสีย จะเจริญเติบโตไม่ได้ ดังนั้นในการหมักเมื่อเกิดกลิ่นแอลกอฮอล์ขึ้น จึงแสดงให้เห็นว่าขบวนการหมักมีคุณภาพและเป็นการหมักที่สมบูรณ์

4. จุลินทรีย์เชื้อรากลุ่มที่เป็นราเส้นใย
จะมีการดำรงชีวิตแบบหลายเซลล์ โดยส่วนใหญ่มีลักษณะการเจิญเติบโตเป็นเส้นใย ซึ่งอาจจะมีผนังกั้น หรือไม่มีก็ได้ เชื้อรากลุ่มนี้เป็นจุลินทรีย์ที่มีความหลากหลาย มีความแตกต่างกันมากในด้านขนาดและรูปร่าง อาศัยการสืบพันธุ์ด้วยการสร้างสปอร์ ซึ่งมีทั้งสปอร์ที่อาศัยเพศและไม่อาศัยเพศ เป็นจุลินทรีย์ที่ต้องการอากาศ พบเห็นอยู่ที่ริมผิวหน้าของน้ำหมักหรือปุ๋ยหมัก
5. จุลินทรีย์กลุ่มแอคติโนมัยซิท (Actinomycetes)
เป็นจุลินทรีย์จำพวกเซลล์เดียว ที่มีลักษณะคล้ายคลึงทั้งแบคทีเรียและเชื้อรา โดยมีขนาดเล็กคล้ายแบคทีเรีย แต่มีการเจริญเติบโตเป็นเส้นใย และสร้างสปอร์คล้ายเชื้อรา มีเส้นใยที่ยาวเรียวและอาจจะแตกสาขาออกไป ส่วนของเส้นใยที่สัมผัสกับอากาศแห้งจะมีการเปลี่ยนรูปไปเป็นสปอร์ ซึ่งใช้ในการแพร่พันธุ์เช่นเดียวกันกับเชื้อรา มีการเจริญเติบโตที่ช้ากว่าแบคทีเรียและเชื้อรา การเจริญเติบโตจะต้องอาศัยอากาศและออกซิเจนในอุณหภูมิ 65-75 องศาเซสเซียส ลักษณะของเชื้อแอคติโนมัยซิทที่พบบนกองปุ๋ยหมักจะเจริญเติบโตเป็นกลุ่ม เห็นเป็นจุดสีขาวคล้ายๆ ผงปูนหลังจากที่อุณหภูมิของกองปุ๋ยสูงขึ้นมาก เชื้อแอคติโนมัยซิทนี้มีบทบาทที่สำคัญในการย่อยอินทรีย์สาร เช่น เซลลูโลส ลิกนิน ไคติน และโปรตีน ที่อยู่ในกองปุ๋ยหมักขณะที่อุณหภูมิสูง
6. จุลินทรีย์กลุ่มที่เป็น สาหร่ายสีเขียวแกมน้ำเงิน (Blue – Green Algae หรือ Cyanobacteria)
แตกต่างจากจุลินทรีย์ชนิดอื่น ตรงที่มีคลอโรฟิลล์ มักเห็นเซลล์เป็นสีเขียว มีลักษณะเซลล์เหมือนแบคทีเรีย สาหร่ายพวกนี้ไม่มีคลอโรพลาสต์ ดังนั้นคลอโรฟิลล์จึงกระจายอยู่ทั่วไปในเซลล์ เจริญเติบโตได้ดีในนาข้าว สามารถตรึงไนโตเจนจากอากาศได้ถึงประมาณ 10-20 กิโลกรัมต่อไร่ มักอาศัยพึ่งพาอยู่กับแหนแดง ซึ่งเป็นเฟิร์นน้ำขนาดเล็กๆ ทำให้แหนแดงเป็ยปุ๋ยพืชสดอย่างดีในนาข้าว
7. จุลินทรีย์กลุ่มโปรโตซัว (Protozoa)
โปรโตซัว เป็นสิ่งมีชีวิตเซลล์เดียวขนาดเล็กที่จัดได้ว่ามีความสำคัญมากในระบบนิเวศ อาศัยอยู่ในน้ำ ในดิน หรือเป็นปรสิต ชนิดที่เป็นปรสิตบางชนิดอาศัยอยู่ในทางเดินอาหารของปลวก เพื่อช่วยย่อยเนื้อไม้ จุลินทรีย์โปรโตซัวมีความสำคัญมากเพราะสามารถย่อยสลายอินทรียวัตถุได้อย่างรวดเร็ว ปัจจุบันจึงมีเกษตรกรนำเอาจาวปลวก มาหมักหัวเชื้อจุลินทรีย์เพื่อนำไปย่อยสลายฟางข้าวในนาและทำปุ๋ยหมัก